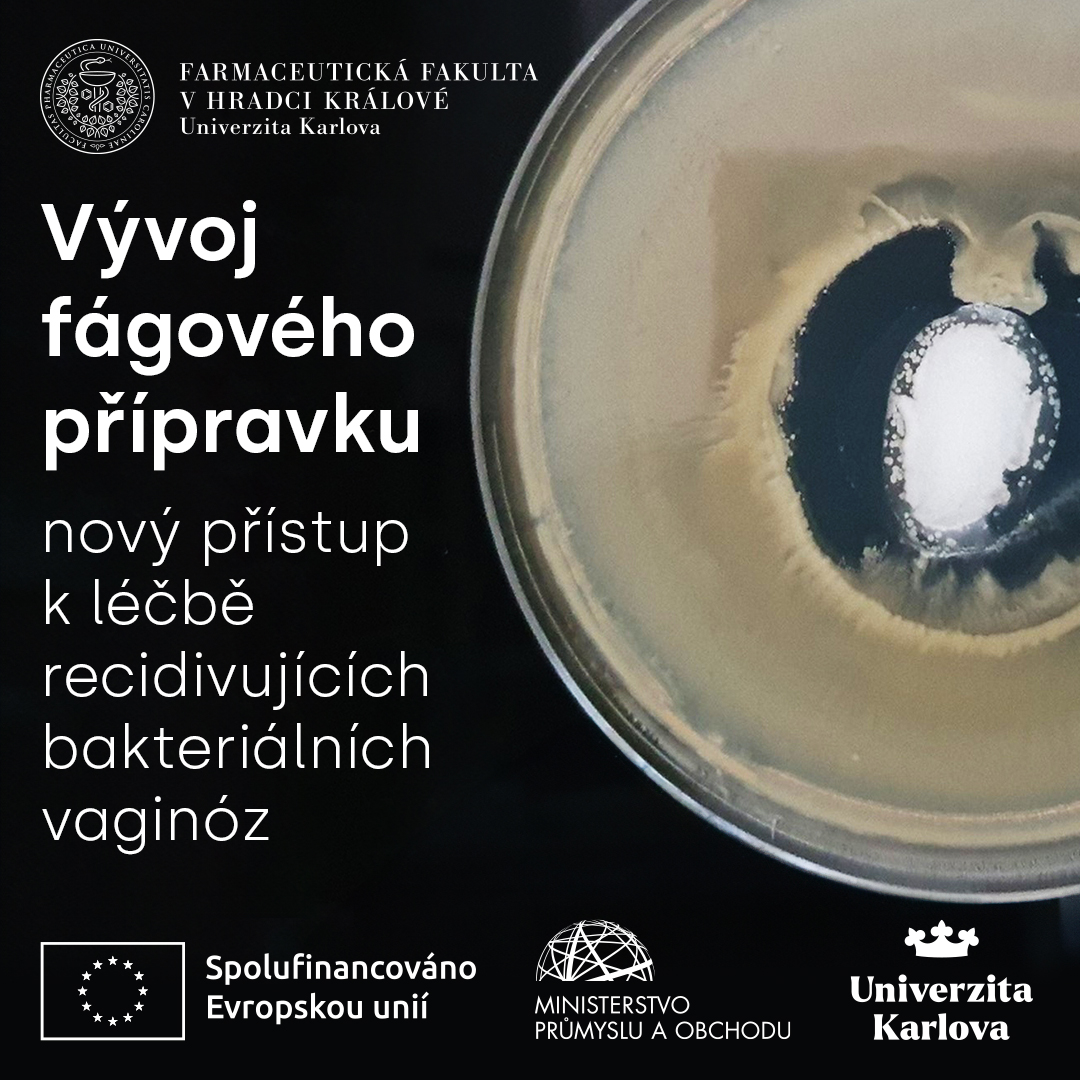
Farmaceutická fakulta UK pracuje na vývoji inovativního antibakteriálního přípravku s obsahem bakteriofágů. Tento lokálně aplikovatelný přípravek je určen k řešení recidivující bakteriální vaginózy.

Více na faf.cuni.cz/Verejnost/Zpra…

Farmaceutická fakulta Univerzity Karlovy
@faf_cuni
Farmaceutická fakulta Univerzity Karlovy v Hradci Králové
ID: 1651492245084725249
https://www.faf.cuni.cz/ 27-04-2023 07:45:45
142 Tweet
118 Followers
36 Following










Prof. Petr Pávek Petr Pavek z Farmaceutické fakulty UK Farmaceutická fakulta Univerzity Karlovy obdržel prestižní ocenění v soutěži Česká hlava. Za objev či mimořádný počin z oblasti zdravotnictví, farmacie a oborů zabývajících se lidským zdravím mu byla udělena cena Lorem. Gratulujeme!


RNDr. Aneta Kholová, Ph.D. z Farmaceutická fakulta Univerzity Karlovy získala prestižní Cenu Dimitrise N. Chorafase. Gratulujeme!